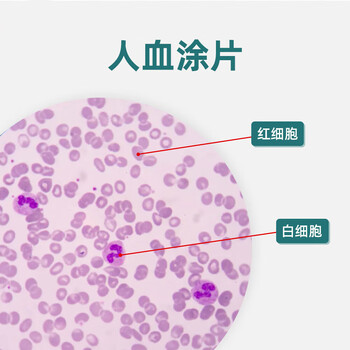
人血涂片标本切片红细胞白细胞显像清晰易观察显微玻片 人血涂片(瑞氏

人血细胞图

如图是"用显微镜观察人血的永久涂片"实验中在显微镜下观察到的血细胞
图片尺寸587x472
血细胞分类,血细胞分类五分类主要看哪几项结果(人体血液的构成)
图片尺寸640x512
红细胞
图片尺寸1080x810
白细胞 红细胞 人的血细胞彩图 血小板
图片尺寸1080x810
观察人血细胞 低倍显微镜下的人血细胞 思考题:为什么在显微镜视野下
图片尺寸1080x810
红色,白色,血细胞
图片尺寸467x350
人血涂片标本切片红细胞白细胞显像清晰易观察显微玻片 人血涂片(瑞氏
图片尺寸350x350
身体内红细胞偏低是什么原因?会产生什么后果?我们该如何预防?
图片尺寸1020x600
1流动的组织--血液二,血细胞(45%): 红细胞 白细胞 血小板 上一页第6
图片尺寸1080x810
红细胞携带氧分子
图片尺寸800x456
红细胞图片
图片尺寸1280x960
红 cloured 血细胞内血管循环三维图照片
图片尺寸450x300
人的血液细胞照片
图片尺寸528x300
红细胞图片
图片尺寸467x350
动物细胞培养ppt
图片尺寸1080x810
混合血液混合的成熟的白色的血细胞向红色的血细胞背景照片
图片尺寸304x300
电子显微镜下的人类细胞
图片尺寸893x391
竖图,许多,科学,很多,粉色,生病,血液,摄影,放大,心血管系统,血细胞
图片尺寸645x819
血液细胞形态学求助
图片尺寸765x1280
人体红色血细胞矢量插画
图片尺寸800x800